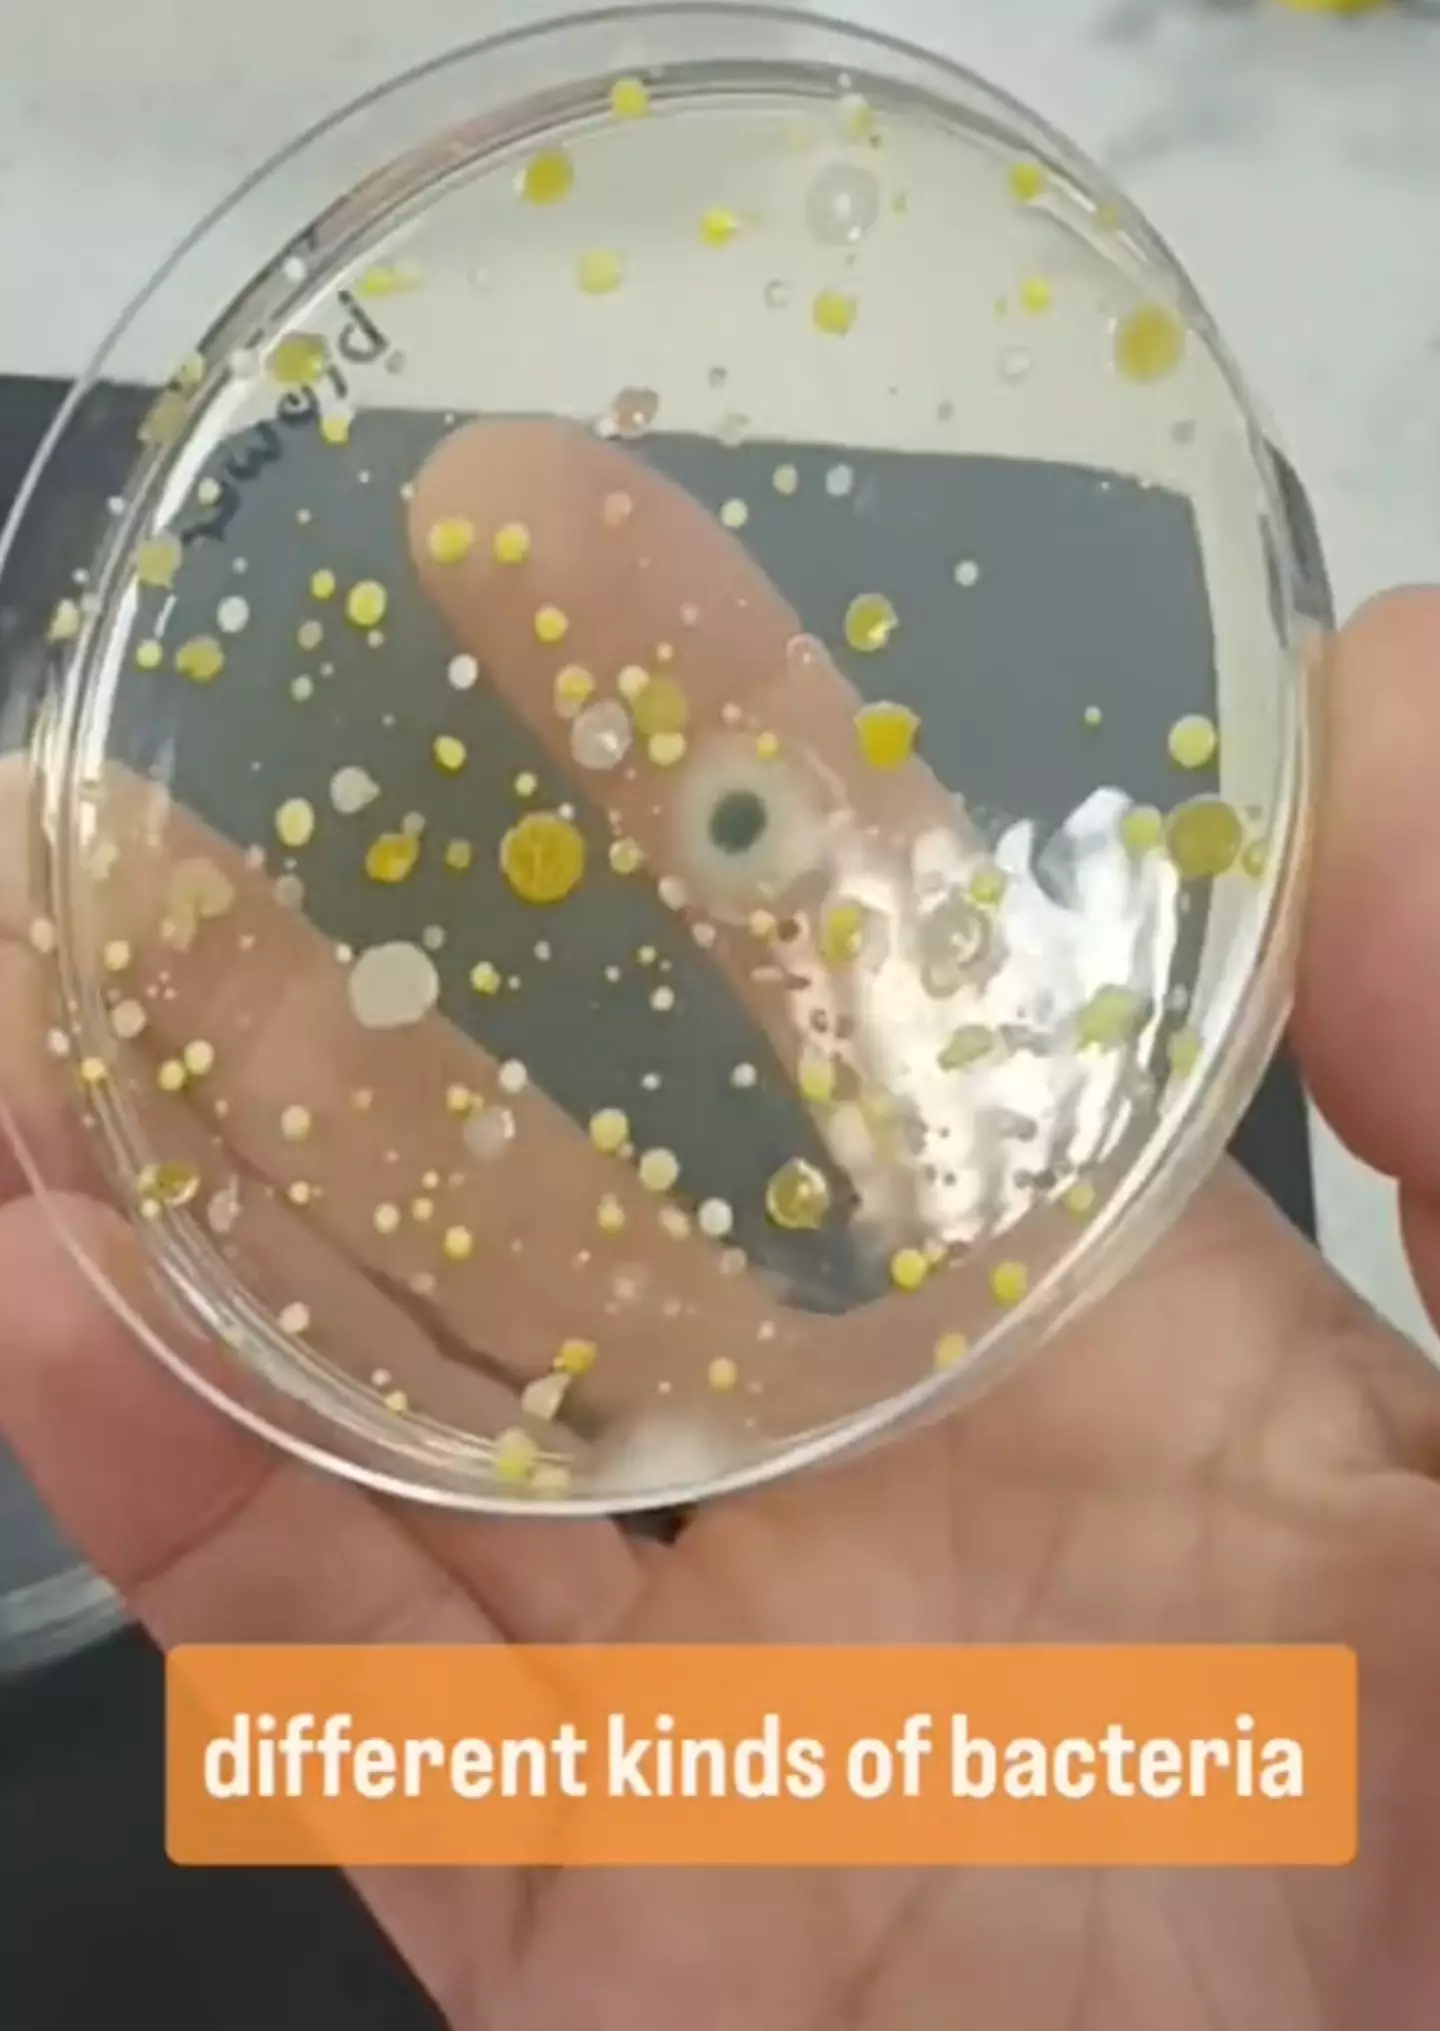

A scientist has revealed just how dirty hand dryers in public bathrooms might be. Prepare to be absolutely disgusted.
Many of us might think that drying our hands using the device is hygienic, but this experiment seems to have proven otherwise.
In recent days, TikTok account Devon Science took to the video sharing platform to share an experiment conducted by Ruth, the scientist who runs the page.
For the test, Ruth took two agar plates (a petri dish with a thin layer of nutrient gel in which is used to grow bacteria and fungi in the microbiology laboratory, for those of you who aren't biologists), and placed one under a hand dryer in a bathroom.
Advert

The other agar plate was then 'wafted around in the air' in a different room for Ruth to later compare the results.
She incubated the two dishes overnight and returned the next day to find different kinds of bacteria in the agar plate that was placed under the hand dryer, as well as fungus.
Meanwhile, the other agar plate grew nothing at all.
Advert
"This is why I do not use hand dryers," Ruth concluded the clip that's since generated over three million views on TikTok.
The video is now putting people off from using hand dryers. One person replied to the viral clip: "I stopped using hand drier after seeing these videos."
"New fear unlocked, cheers," said another.
Advert
A different person went on: "Ha knew it. Never using them again."
Elsewhere, dozens of others asked Ruth to do the same test on a Dyson hand dryer as the company claims that's tech uses HEPA filtration to dry hands with purified air.
Ruth has since promised that she'll do another test using the Dyson device.
In the wake of her video going viral (pun intended), Ruth has posted another video discussing it further and addressed some people's criticisms of the test being invalid.
Advert
She said: "It's not a proper scientific experiment, I literally had two spare agar plates and I thought 'what am I going to do with these?'"
Ruth's idea to test the hand dryer came off the back of a conversation she had with a friend a few weeks ago.
She described it as 'a very simple test' and expressed her desire to do more.
Advert
"Don't take them too seriously, it's just a bit of fun," Ruth went on to warn.
Fun or not, I'll definitely think twice about using a hand dryer in the future.